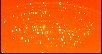

|
XSHOOTER raw files (date: 2025-12-22) |
This is the raw file monitor with screenshots of raw calibration data. There is one page per raw data type. All files taken in the same template are displayed in the same row.
The number of displayed files per template is limited depending on raw type and instrument. Files which are not displayed have a placeholder ("n/c", i.e. "not configured").
Files that could not be downloaded from the archive are marked as "not yet available".
Use the 'jump' button to jump to a specific set of raw displays, labelled by their AB name.
Click on the thumbnails to get a larger display together with histograms and cuts. Find more information in the help.